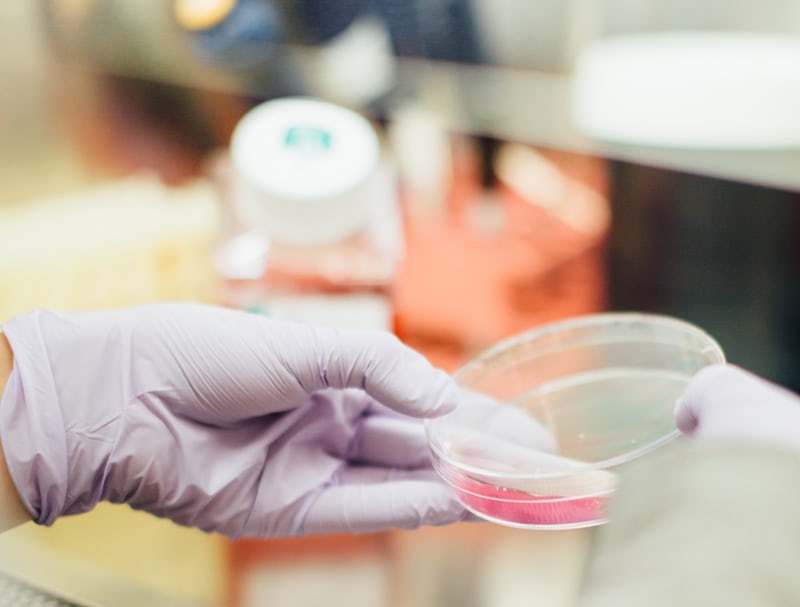
乙肝什么情况下可以打干扰素,乙肝干扰素治疗的好处与坏处

在介绍2019年新版指南中口服抗病毒药物的选择以及停药时机后,不少战友对于另外一种抗病毒药物存有疑问。新版指南中对于干扰素的治疗是如何建议的呢?让我们一起来回顾一下相关背景知识,并了解新版指南中关于干扰素的部分!
首先,与口服抗病毒一线药物恩替卡韦、TDF、TAF不同的是,干扰素不是直接作用于细胞的复制过程,它作用于免疫细胞促使免疫细胞表达分泌抗病毒蛋白从而间接地达到抗病毒效果。

其次,干扰素对于病毒没有特异性,具有广谱的抗病毒作用。
另外,除了抗病毒干扰素在人体中还具有抗肿瘤调节免疫等多种生物功能。
目前批准用于慢性乙肝治疗的干扰素有两种:PegIFNα和IFNα。PegIFNα相对来说属于长效制剂,对于乙肝患者的注射更加方便。

那么干扰素治疗有哪些优势和缺点呢?我们通过以下几个回答来解决大家的疑问~
1. 干扰素的治疗方案以及疗效是怎样?
初始单药治疗:
多项临床试验(多中心、随机、对照)显示,HBeAg阳性CHB患者采用PegIFNα-2a或国产PegIFNα-2b治疗48周(180 mg/周),HBsAg转换率为2.3%~3%,停药3年HBsAg清除率为11%。
PegIFNα-2a治疗HBeAg阴性慢性HBV感染者(60%为亚洲人)48周, HBsAg消失率在停药随访24周、3年、5年时分别为3%、8.7%和12%。
另外,一项包括682例采用NAs、430例应用IFNα单独或联合NAs治疗的回顾性研究显示,在中位随访时间5.41年时共31例发生肝细胞癌,接受IFNα治疗患者的10年累积肝细胞癌发生率明显低于NAs治疗患者(2.7%比8.0%,P< 0.001)。
所以说,从一开始就只使用干扰素初治患者的消失率相比口服核苷类似物明显高很多,干扰素抗病毒更容易达到临床治愈的目的,同时可以有效降低因乙肝病毒(即HBV)所导致肝癌的发病率。
2. 哪些人群使用干扰素会有更好疗效?
治疗前的预测因素有:
HBV DNA<2×108 IU/mL,ALT高水平(2~10×ULN)或肝组织炎症坏死G2以上,A或B基因型,基线低HBsAg水平(<25 000 IU/mL),基线核心抗体定量检测(qAnti-HBc)定量高水平,基线信号转导及转录激活蛋白4 ( Signal transducer and activator of transcription,STAT4)为rs7574865,是提示IFN疗效较好的预测指标。Peg-IFN-α治疗12周时的HBV DNA水平、HBsAg定量及其动态变化,可用于预测IFN疗效。
因此,我们可以发现ALT高水平的患者使用干扰素治疗或许可以获得更好的疗效!
在接下来的文章中我们将继续为各位战友介绍新版指南中干扰素的治疗相关的内容!大家不要错过哦!